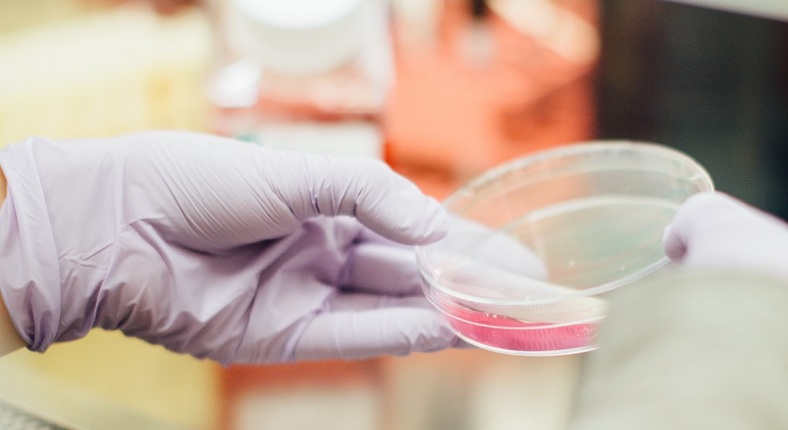
BeFoodTech's tweet image. Kweekvis als alternatief voor de visvangst ow.ly/BJ8x50ywcZH

BeFoodTech
@BeFoodTech
Opleidingen, vacatures en nieuws over voedingstechnologie / Formations, offres d’emploi et des nouvelles concernant la technologie alimentaire
Potrebbero piacerti
Op het #FoodForwardEvent organiseert @kdeschrijver van @AlimentoGroep een workshop over één van de grootste uitdagingen van voedingsbedrijven: het aantrekken en behouden van #STEM-talent. Schrijf je in en ervaar zelf hoe 3D-brillen👓daarbij kunnen helpen! fevia.be/nl/workshop-5-…
La promesse des industriels de l’agroalimentaire : 56 tonnes d’emballages en moins dhnet.be/conso/consomma… @BeFoodTech @fevia_be
Soyez des nôtres le mercredi 29 avril prochain pour découvrir les aliments de demain imaginés par les jeunes aujourd’hui ! @BeFoodTech @AlimentoGroupe @foodatworkFR #passion4food
Lors du #FoodForwardEvent le 29 avril prochain, trendwatcher @palmaerts nous emmène dans le futur. Are you ready? Inscrivez-vous sur foodforwardevent.be et découvrez à quoi rassemblera notre alimentation en 2030!
La digitalisation dans l’usine alimentaire… et au-delà fevia.be/fr/actualites/…
fevia.be
La digitalisation dans l’usine alimentaire… et au-delà | Fevia
Avez-vous déjà franchi les portes d’une entreprise alimentaire belge ? Vous avez dans ce cas dû remarquer une usine pleine d’outils technologiques et digitaux qui permettent d’organiser de manière...
Vers des emballages toujours plus durables rtbf.be/auvio/detail_v… via @BeFoodTech @foodatworkFR
Student-ingenieurs werken mee aan gezonde kinderkoekjes ugent.be/bw/nl/actueel/… via @ugent @BeFoodTech @fevia_be
Vandemoortele Izegem mag zich sinds 19 februari #FactoryoftheFuture noemen. Het voedingsbedrijf scoorde met name met de wisselwerking tussen mens en de productie-installaties ow.ly/lTFy50yu3Cl

Elke twee jaar gaat vakbeurs @TAVOLA_XPO op zoek naar veelbelovende innovaties in de #voedingssector. Dit jaar ging de jury resoluut voor gezond, plantaardig, natuurlijk en duurzaam. Maak kennis met de laureaten - ow.ly/lLaz50yu3LQ
Salon du chocolat : Vitrine pour les producteurs de fèves et un véritable plaisir pour le palais ! Journal télévisé - Sujet par sujet : sur Auvio ow.ly/6CeM30qizqJ
Insectenvet in plaats van boter in gebakjes en andere bereidingen? Volgens onderzoek van UGent kan het perfect: vervang in een gebak de helft van de boter met insectenvet en je proeft het verschil nauwelijks. Het voordeel: insectenvet is duurzamer - gondola.be/nl/news/binnen…
Nourritures ou objets, plusieurs entreprises se sont lancées dans le recyclage de ces résidus de bières ow.ly/jn3C50ybPfj
In de zoektocht naar diervriendelijke alternatieven voor vlees en vis wordt steeds meer gekeken naar #spitstechnologie. De volgende stap: scampivlees dat wordt opgekweekt in een laboratorium ow.ly/oVzc50ybPcB
Bientôt des pailles en papier sur les berlingots de Cécémel, Fristi et Joyvalle ow.ly/cxaG50y5Hbt

United States Tendenze
- 1. $GHOST N/A
- 2. Good Thursday N/A
- 3. Rafael Tudares N/A
- 4. Wawrinka N/A
- 5. Board of Peace N/A
- 6. #QG542 N/A
- 7. Cyraxx N/A
- 8. DataHaven Testnet N/A
- 9. Naomi Osaka N/A
- 10. Fredo N/A
- 11. Cuomo N/A
- 12. Brewers N/A
- 13. Peralta N/A
- 14. Lagos N/A
- 15. Hathaway N/A
- 16. #ArknightsEndfield N/A
- 17. #AEWDynamite N/A
- 18. #AusOpen N/A
- 19. $SKR N/A
- 20. #AustralianOpen N/A
Potrebbero piacerti
Something went wrong.
Something went wrong.